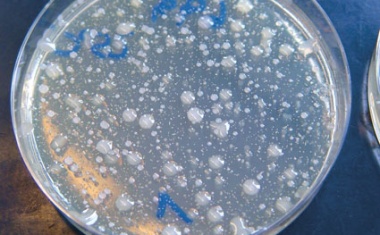
Photo

Paracelsus-Medaille für Bonner Hygieniker Bundesärztekammer ehrt Prof. Dr. Martin Exner
Die Bundesärztekammer hat Prof. Dr. med. Martin Exner, emeritierter Professor von der Universität Bonn, mit der Paracelsus-Medaille ausgezeichnet.

Die Bundesärztekammer hat Prof. Dr. med. Martin Exner, emeritierter Professor von der Universität Bonn, mit der Paracelsus-Medaille ausgezeichnet.

Wirksame Barriere oder nur Kosmetik? Gram-negative Bakterien und ihre Resistenzen rücken zu Recht immer mehr in den Fokus der Aufmerksamkeit.

Gegen die Kostenexplosion in Kliniken ist beispielsweise energieeffiziente Gebäudetechnik von Nutzen. Die oft maroden Anlagen verursachen hohe Kosten bei Heizmittel-, Dampf- und Stromverbrauch.

Fast 50 Jahre nach dem ersten Todesfall sind Legionellen immer noch eine weithin unterschätzte Gefahr – besonders für immungeschwächte Menschen.

Leibniz-Gründungspreis 2021 geht nach Frankfurt (Oder) und Greifswald.